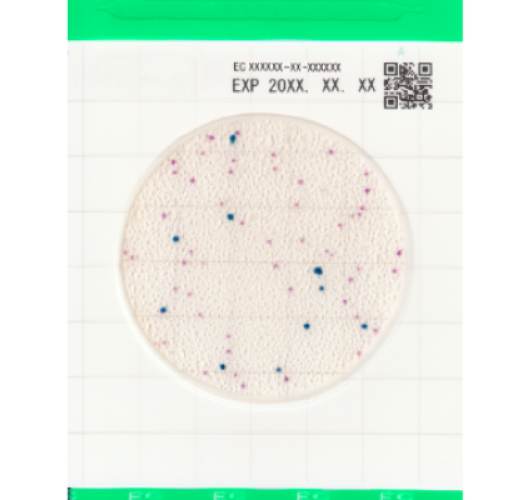
E.Coli и Колиформы - Easy Plate EC

E.Coli и Колиформы - Easy Plate EC
Категория:
Microorganism: Escherichia coli O157, Eschrichia coli, Koliform
Производитель:
E.Coli и Колиформы - Easy Plate EC — это удобная пластина со средой для обнаружения, идентификации и подсчета кишечной палочки и не относящихся к E. coli колиформ.
Анализ завершается примерно через 24 часа с помощью пластины для микробиологического тестирования, содержащую два хромогенных субстрата, благодаря которым E.coli приобретает цвет от сине-фиолетового до темно-синего, тогда как колиформы, не относящиеся к E.coli, имеют цвет от розового до красно-фиолетового. Четкая окраска колоний облегчает тестирование и подсчет кишечной палочки и колиформ.
Не требующая подготовки или стерилизации.
Время инкубации: 24 ± 1 час
Температура инкубации: 35±1℃
Температура хранения: 2 - 8℃
Срок годности: 18 месяцев
Упаковка: 100 тестов (25 тестов х 4 пакета)